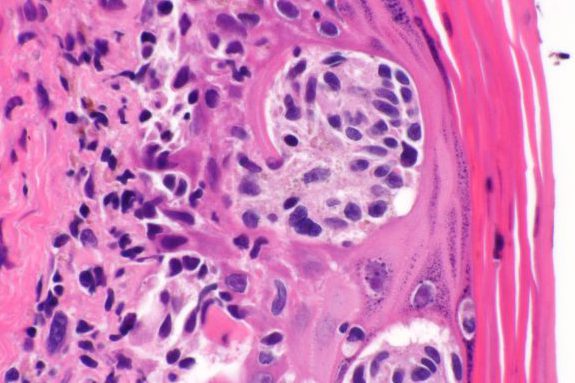
3.  Melanoma (MC)

La prevenzione resta la chiave
Riconoscere un tumore cutaneo in fase precoce significa, nella maggior parte dei casi, poterlo curare con successo.
In Svizzera, i tumori della pelle non melanoma mostrano tassi di guarigione prossimi al 99% quando identificati e trattati tempestivamente. Anche per il melanoma, se diagnosticato allo stadio iniziale, la prognosi è molto favorevole.
- Tassi di sopravvivenza elevati: per i melanomi diagnosticati in fase iniziale, la sopravvivenza a 5 anni supera il 90–95%.
- Mortalità tra le più basse in Europa: grazie ai programmi di screening e alla qualità delle cure, in Svizzera molti tumori vengono identificati e trattati prima che diventino pericolosi.
Il messaggio più importante è uno: se hai una lesione sospetta, non aspettare. Una diagnosi precoce può fare la differenza.
La Causa: Perché il melanoma è così diffuso in Svizzera?
In oltre il 90% dei casi, la causa principale è l’esposizione ai raggi UV.In Ticino, la combinazione di attività frequenti all’aperto, un clima molto soleggiato e una pelle spesso chiara aumenta ulteriormente il rischio.Riconoscere i principali fattori di rischio permette una prevenzione efficace.
I fattori che più incidono sono:
- Raggi UV, scottature solari, solarium, fototipo I/II, l'età.
- Se presenti uno o più di questi fattori, è consigliabile una valutazione specialistica
Prenota una visita di prevenzione
Invia una foto per una valutazione gratuita

Raggi UV
L’esposizione al sole (UVA/UVB) è la causa n.1.

Scottature Solari
Soprattutto quelle in età infantile.

Solarium
Aumentano significativamente il rischio.

Fototipo I/II
Pelle chiara, occhi chiari, capelli biondi/rossi.

L’età
Più si è avanti con l’età, più il sole causa danni

Un impegno per la Svizzera
Proteggere la salute della pelle in Svizzera è la nostra missione
Vivere tra laghi e montagne significa godere di un’esposizione solare unica.
Ma proprio questo stile di vita ci espone anche a un rischio maggiore di tumori cutanei.
In Svizzera i casi sono in aumento costante. Per questo abbiamo creato questo spazio dedicato: informazione affidabile, diagnosi precoce e trattamenti specialistici sono le armi più efficaci che abbiamo per proteggere la tua salute.
Il nostro obiettivo è semplice: essere il punto di riferimento per la diagnosi e il trattamento dei tumori cutanei in Svizzera.

Carcinomi cutanei Non-Melanoma (NMSC) vs. Melanoma
I tumori cutanei Non-Melanoma come carcinoma basocellulare e squamocellulare sono molto comuni in Svizzera (20.000–25.000 casi/anno) ma raramente pericolosi se trattati tempestivamente.
Il melanoma, invece, è meno frequente (circa 3.000 casi/anno) ma può essere molto più aggressivo se non diagnosticato precocemente.
Causa: esposizione solare cumulativa.
Cosa significa per te: una diagnosi precoce fa la differenza tra un trattamento semplice e uno più complesso.
Stime annue in Svizzera

Melanoma: incidenza e mortalità per genere
Il melanoma colpisce entrambi i sessi, con un’incidenza leggermente superiore negli uomini, spesso per diagnosi più tardive e minore protezione solare.
Causa principale: scottature intense, soprattutto durante l’infanzia.
Cosa significa per te: anche una sola scottatura importante può aumentare significativamente il rischio.
Valuta il tuo rischio gratuitamente
Stime annue in Svizzera
I 3 tipi principali di tumori cutanei
Non tutti i tumori cutanei sono uguali. Conoscerli aiuta a capire il rischio.
1. Basalioma (BCC)
Il tumore cutaneo più comune. Cresce lentamente e metastatizza molto raramente. Si presenta come una “perla” rosa, una lesione traslucida o una ferita che non guarisce. Rischio Basso.

2. Spinalioma (SCC)
Il secondo più frequente. Può crescere più rapidamente del BCC e ha un rischio moderato di metastasi. Si presenta come un nodulo duro, una crosta persistente o una lesione ulcerata.
Rischio Moderato.

3. Melanoma (MC)
Il più raro ma il più pericoloso: può dare metastasi rapidamente se non diagnosticato precocemente. Nasce da un neo esistente o da pelle sana. Rischio Alto.

Come riconoscere un tumore della pelle
L’autoesame è il primo passo per individuare cambiamenti sospetti sulla pelle. Riconoscere i segnali giusti e rivolgersi rapidamente a uno specialista può fare una grande differenza.

La ricostruzione fa la differenza: funzionale, naturale, armoniosa
Rimuovere un tumore cutaneo è solo il primo passo.La ricostruzione richiede precisione chirurgica, conoscenza anatomica avanzata e sensibilità estetica, soprattutto nelle aree più delicate del viso.
Ogni intervento viene pianificato su misura, con tecniche che garantiscono il miglior risultato possibile in termini di funzione, simmetria e naturalezza.

La ricostruzione fa la differenza: funzionale, naturale, armoniosa
Rimuovere un tumore cutaneo è solo il primo passo.La ricostruzione richiede precisione chirurgica, conoscenza anatomica avanzata e sensibilità estetica, soprattutto nelle aree più delicate del viso.
Ogni intervento viene pianificato su misura, con tecniche che garantiscono il miglior risultato possibile in termini di funzione, simmetria e naturalezza.

Il 99% dei tumori cutanei è curabile se scoperto in tempo.
Controlla regolarmente la tua pelle e non ignorare i cambiamenti: la diagnosi precoce fa la differenza.
Neo sospetto? Non aspettare
Anche una piccola variazione può essere significativa. Ecco i due percorsi più rapidi per farti valutare da un medico:
Controllo in clinica
Il modo più accurato per valutare la tua pelle.Visita specialistica completa con dermatoscopia e, se necessario, mappatura digitale.
Valutazione digitale gratuita
Una sola macchia ti preoccupa?Invia una foto in modo sicuro: uno specialista ti darà un primo parere rapido.
